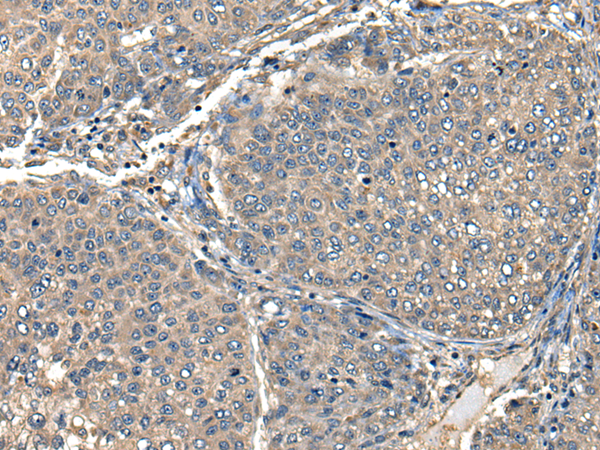

|
Background: |
This gene encodes a protein that plays an important role in the immune response. This protein is a high-affinity Fc-gamma receptor. The gene is one of three related gene family members located on chromosome 1. |
|
Applications: |
ELISA, IHC |
|
Name of antibody: |
FCGR1A |
|
Immunogen: |
Synthetic peptide of human FCGR1A |
|
Full name: |
Fc fragment of IgG receptor Ia |
|
Synonyms: |
CD64; FCRI; CD64A; IGFR1 |
|
SwissProt: |
P12314 |
|
ELISA Recommended dilution: |
5000-10000 |
|
IHC positive control: |
Human liver cancer |
|
IHC Recommend dilution: |
30-150 |
購(gòu)物車(chē)
幫助
021-54845833/15800441009
